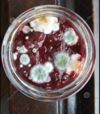
1656065522461.png

balmainforever
Dibs
- Sep 4, 2003
- 26,617
- 31,768
- AFL Club
- Richmond
- Other Teams
- Balmain, GreenBay, Edmonton, Celtic
- Thread starter
- Moderator
- #23
POSTING OF BETS AND RESULTS AFTER THE FACT WILL NOT BE TOLERATED ANYMORE!!
ANYONE WHO DOES IT WILL BE GIVEN A HOLIDAY.
CONSIDER THIS EVERYONE'S FINAL WARNING!!!!!!
ANYONE WHO DOES IT WILL BE GIVEN A HOLIDAY.
CONSIDER THIS EVERYONE'S FINAL WARNING!!!!!!